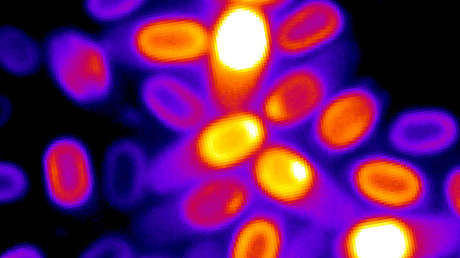
Descubren que bacterias "muertas" pueden volver a la vida

Un grupo de científicos liderado por Sergiu Pasca, profesor de psiquiatría en la Escuela de Medicina de la Universidad de Stanford (EE.UU.), logró crear una especie de cerebro híbrido tras implantar células humanas en ratones de laboratorio. Los resultados de su experimento fueron publicados este 12 de octubre en la revista Nature.
Los especialistas lograron influir en el comportamiento de los roedores, así como también profundizar el conocimiento sobre enfermedades como el autismo y la epilepsia.
En la investigación, los científicos recurrieron al método descrito por Pasca en 2015 para crear células cerebrales utilizando células madre, que son capaces de transformarse en la mayoría de los tipos de células del cuerpo humano. Multiplicaron estas células en placas de laboratorio para formar grupos celulares parecidos a la corteza cerebral humana, denominados organoides.
Aproximadamente dos meses después, los expertos injertaron los organoides en el cerebro de los ratones, ubicándolos exactamente en el mismo sector de sus cerebros para observar mejor la reacción. Como resultado, las células animales se desplazaron hacia el tejido humano, se reseña en un comunicado de la Universidad de Stanford. Los organoides implantados no solo sobrevivieron, sino que también crecieron hasta ocupar un tercio del hemisferio del cerebro de los roedores, aunque seis meses antes medían un quinto de pulgada.
Además, los investigadores observaron que las neuronas humanas eran seis veces más grandes que las de los organoides sin implantar. Asimismo, advirtieron que las neuronas de los organoides establecieron vínculos con las estructuras cerebrales de los roedores, por ejemplo, con el tálamo, una región profunda del cerebro que transmite diferentes señales sensoriales a la corteza.
Por otra parte, el grupo de científicos logró ampliar su conocimiento sobre el síndrome de Timothy, una rara enfermedad congénita asociada al autismo y la epilepsia. En concreto, injertaron un organoide generado a partir de las células cutáneas de un paciente con dicho mal en un sector cerebral de un ratón. En una zona ubicada al otro lado del cerebro, trasplantaron un organoide derivado de un individuo sano.
Entre cinco y seis meses después, observaron diferencias sustanciales entre la actividad eléctrica a ambos lados, mientras que las neuronas del organoide con síndrome de Timothy eran mucho más pequeñas.
¡Hay reacción!
Como los organoides fueron colocados en el sector del cerebro que procesa la información proveniente de los bigotes de los animales, los especialistas demostraron que las neuronas humanas se activan cuando reciben señales de los órganos sensoriales ratoniles. Así, al hacerles cosquillas con aire en los bigotes, las neuronas se volvían eléctricamente activas.
En otro experimento, se logró controlar el comportamiento de los roedores usando células cerebrales humanas sensibles a la luz. Cada vez que los animales querían beber agua, los científicos empleaban ráfagas de luz azul para activar el tejido del organoide humano (el agua solo estaba disponible después de aparecer la luz). Al cabo de dos semanas, bastaba con pulsar la luz azul en el organoide y los animales empezaban a correr hacia el agua.